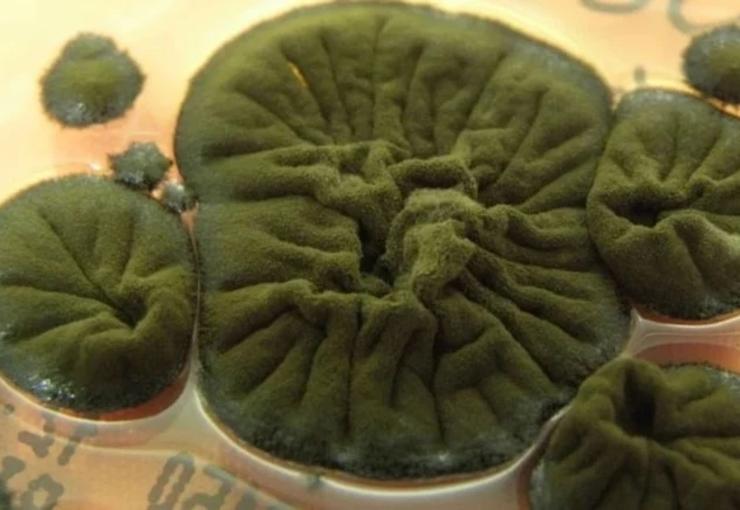
437743

Çernobil'de ortaya çıkan mantar şoke etti: Radyasyon yiyerek büyüyor
Çernobil’in harabeye dönmüş, yıllardır kimsenin yaklaşmaya cesaret edemediği o ölümcül atmosferinde beklenmedik bir hayat formu ortaya çıktı. Felaketin gölgesinde doğan bu siyah mantarlar sıradan bir dayanıklılığın ötesinde bir özellik taşıyor.
Çernobil felaketinin derinliklerinde şaşırtıcı bir buluş. 1986 Çernobil patlaması ve yangını, dünyanın en ölümcül bölgelerinden birinin doğmasına neden oldu. Daha sonra bilim insanları, kimsenin beklemediği bir yaşam formunu keşfettiler. Cladosporium sphaerospermum, aslında radyoaktivitede daha hızlı büyüyen siyah, radyo aktiviteyi yiyen bir mantar olarak tanımlanıyor.
Siyah Mantar'ın biyolojik zırh gibi çalışan bölümü hücre duvarlarındaki siyah melaninidir. İnsanda bu pigment cildi UV ışınlarından korurken, mantarlarda iyonlaşan radyasyona karşı bir kalkan görevi görür. Radyasyonu emer ve dağıtır ve bazı deneylerde mantarın büyümesi sırasında radyasyonun enerjisinde bile rol oynar.
Nükleer bilim insanı Ekaterina Dadachova'nın 2007'de keşfettiği mantar ilgi çekmeye devam ediyor. Gündem olan mantarların fotoğrafları, radyoaktif bozunma sırasında büyümelerini %10 daha hızlı artırdıkları tespit edilmesini sağladı. Bilim camiası bu sürece 'radyo sentez' adını vermeye başladı; bu da 'radyasyondan beslenmek' anlamına gelmektedir.
UZAYDA DAHA DA HIZLI BÜYÜDÜLER
Bu şaşırtıcı davranış sadece Çernobil’le sınırlı kalmadı. 2018’de Uluslararası Uzay İstasyonu’na gönderilen aynı mantar türü, Dünya’daki örneklerine göre yüzde 21 daha hızlı büyüdü. Deneylerde mantarın altına yerleştirilen ölçüm cihazları, ince bir mantar tabakasının bile uzay radyasyonunun bir kısmını engellediğini ortaya koydu.
Uzay üsleri için biyolojik kalkan fikri
Bu sonuçlar özellikle Ay ve Mars yüzeyinde kurulması planlanan geleceğin uzay üsleri için kritik önem taşıyor. Astronotlar bu ortamlarda Dünya’dakinin yüzlerce katı kozmik ışınla karşı karşıya kalıyor. Geleneksel koruyucu malzemeler ağır olduğu için uzaya taşınmaları hem zor hem de maliyetli.
Bu yüzden NASA’daki bazı araştırmacılar, gelecekte astronot barınaklarının duvarlarının bu mantarlardan “büyütülebileceğini” düşünüyor. Böylece uzay kolonilerinin kendi kendine yenilenebilen hafif ve etkili bir biyolojik radyasyon kalkanına sahip olması mümkün olabilir.
Çernobil’in ölümcül ortamında hayatta kalan bu siyah mantarlar bir zamanlar felaketin simgesiydi. Bugün ise ironik bir biçimde insanlığı uzayın ölümcül radyasyonundan koruyabilecek umut verici bir araca dönüşmüş durumda.
sözcü
Yorum Ekle
Diğer Haberler
'Görünmez' Avrupa ülkesi turizmde patlama yaşadı
Avrupa gezilerinde çoğu kişi Paris, Prag ya da İspanyol sahillerini düşünse de istatistikler başka bir ülkeyi zirveye taşıdı. Türklerin vizesiz olarak seyahat edebildiği Moldova'da 2025'i...
Kritik Dosya Yeniden Gündemde! Netanyahu Hakim Karşısında
İsrail Başbakanı Binyamin Netanyahu, af başvurusunun ardından yolsuzluk suçlamalarıyla ilgili davalarda ilk kez hakim karşısına çıktı.
Rusya'dan Çin'e vize uygulamasını kaldırma kararı
Rusya, Çin vatandaşlarına yönelik vize uygulamasını kaldırılma kararı aldı. Devlet Başkanı Vladimir Putin, Çinli ziyaretçilerden vize talep edilmemesini öngören kararnameyi imzaladı.
Azerbaycan’da muhalefet lideri gözaltına alındı
Azerbaycan Halk Cephesi Partisi Genel Başkanı Ali Kerimli’nin güvenlik güçlerince gözaltına alındığı bildirildi. Kerimli’nin danışmanı Fuad Gahramanlı, Kerimli’nin telefonlarına ulaşılama...
Portekiz veya İspanya değil: Emeklilik için en iyi ülke açıklandı, şaşırtıcı
International Living’in 2026 Emeklilik Endeksi, yıllardır listenin favorileri olan Portekiz ve İspanya’nın tahtını salladı. Beklenmedik bir ülke zirveye yerleşti. Her yıl yüz binlerce kiş...
Trump’tan Maduro’ya ‘derhal git’ ültimatomu
ABD Başkanı Donald Trump’ın Nicolás Maduro’ya “derhal istifa et” ültimatomu verdiği ve buna karşılık Caracas’ın küresel af ve ordu kontrolü talebi üzerine görüşmelerin tıkandığı öne sürüldü.
PKK’dan küstah açıklama! Abdullah Öcalan şartı
Terör örgütü PKK’nın sözde yöneticileri, AFP’ye yaptıkları açıklamada Abdullah Öcalan serbest bırakılmadan hiçbir adım atmayacaklarını bildirdi. Terör örgütü PKK’nın sözde yöneticilerinde...
Trump: 'Venezuela hava sahası tamamen kapandı'
ABD Başkanı Donald Trump Venezuela hava sahasının kapatılacağını açıkladı. Sosyal medya mesajında havayollarını, pilotları, uyuşturucu ve insan kaçakçılarını uyardı. Çıkış Trump ile Madur...
SOSYAL MEDYA
MAGAZİN
Burak Özçivit Rusya'da kral ilan edildi, 20 milyon aldı
Son olarak 'Kuruluş Osman' dizisinde yer alan oyuncu Burak Özçivit, önceki gün Rusya'nın Astrakhan şehrinde bir etkinliğe katıldı. Etkinlikte kral ilan edilen Özçivit'in 20 milyon TL aldı...
TEKNOLOJİ
EDİTÖR'ÜN SEÇTİKLERİ
Günde ne kadar C vitaminine ihtiyacımız var?
Kış hastalıklarının kapıda olduğu bugünlerde C vitamini bağışıklık sistemimizi güçlendiren antioksidan olarak öne çıkıyor. İşte bu vitamini doğal yoldan ve yeteri kadar alma yolları. Kış aylarında soğuk algınlığı ve grip gibi hastalıklar artarken hastalıklara karşı kalkan görevi gören C vitamini önem kazanıyor.










































Yorumlar
Bu haberde yorum bulunmamaktadir.